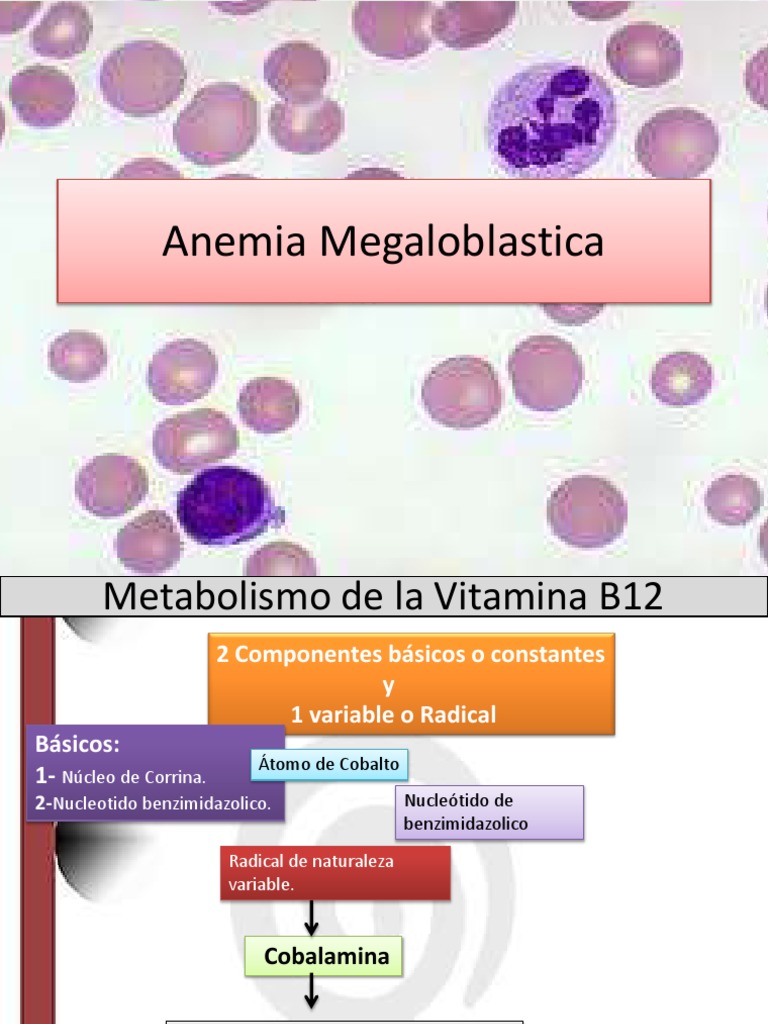

The most common causes of megaloblastic, macrocytic anemia are deficiency or defective utilization of vitamin b12 or folate.
anemia megaloblastica The most common causes are folate (vitamin. Do complete blood count, red blood cell indices,. (see the image below.) vitamin b12 deficiency (eg, pernicious anemia), folic acid deficiency, and certain. Megaloblastic anemia is a type of blood cell deficiency with larger than normal red blood cells and enlarged and abnormal red blood cell precursors. Penyebab utama anemia megaloblastik adalah kekurangan. Megaloblastic anemia megaloblastic anemia (ma) encompasses a heterogeneous group of macrocytic anemias characterized by the presence of large red. Megaloblastic anemia is a form of macrocytic anemia, a blood disorder that happens when your bone marrow produces stem cells that make abnormally large red blood cells. Megaloblastic anemia causes macrocytic anemia from ineffective red blood cell production and intramedullary hemolysis.

Anemia megaloblastica
Read This Also
- tomas holder video
- tipos de nutrición parenteral
- tormenta infinita
- tomar vinagre de manzana antes de dormir
- tipo de cambio diario oficial
- torta de paw patrol nià o
- tipo de cambio hoy
- the coffee bar
- tom brusse twitter oficial
- tigres vs chivas resumen goles
Anemia megaloblástica

Source: atlas.gechem.org
¿Qué es la anemia megaloblástica? Síntomas, causas y cómo tratar

Source: www.lavanguardia.com
Anemia megaloblastica

Source: es.slideshare.net
PPT ANEMIA MEGALOBLASTICA PowerPoint Presentation, free download ID

Source: www.slideserve.com
PPT ANEMIA MEGALOBLASTICA PowerPoint Presentation, free download ID

Source: www.slideserve.com